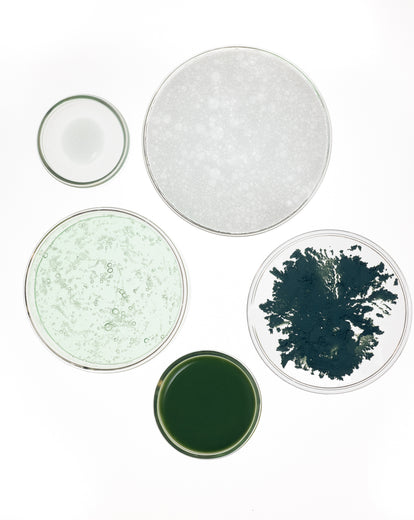

[VRAIE PEAU, VRAIE SOLUTION]

@anaelle

@djavan

@chloé

Résultats
2x
moins de boutons après 28 jours d'application du Sérum Purifiant.*
91%
constatent un grain de peau plus lisse après l'usage du Gel Nettoyant.**
100%
affirment que le produit prévient leurs imperfections, après l'usage du Masque.***
3h
après application du Soin Flash, le bouton est visiblement réduit.****
*Scorage clinique, 20 volontaires, 28 jours.
**Etude clinique, 22 volontaires, 14 jours.
***Etude Clinique, 22 volontaires, 14 jours.
****Test instrumental par analyse d’image, 21 volontaires, 3H après application.


Composé de dermatologues, d’experts en formulation et d’un Docteur en pharmacie
✓ Peaux mixtes à grasses sujettes aux brillances et à l’excès de sébum
✓ Imperfections récurrentes (boutons, points noirs) et pores visibles
✓ Poussées ponctuelles liées au cycle, au stress ou à la chaleur
✓ Recherche d’une peau nette et matifiée, sans dessécher
Matin et soir,
1 - Appliquez sur visage humidifié le Gel Nettoyant Purifiant. Massez légèrement votre peau afin d’obtenir une mousse onctueuse, puis rincez.
2 - Ensuite, appliquez le Sérum Concentré Purifiant sur l’ensemble du visage et du cou. Massez pour faire pénétrer.
3- Puis, appliquez généreusement le Fluide Hydratation Intense SPF 30 sur l’ensemble du visage et du cou. Massez pour faire pénétrer.
Deux fois par semaine,
Appliquez le Masque stick Peau Nette après votre Gel Nettoyant Purifiant et sèche puis laissez poser 5 minutes. Rincez.
Ponctuellement jusqu'à 3 fois par jour,
Appliquez localement le Soin Flash Boutons sur l’imperfection, puis laissez sécher.
✓ Terminez toujours par votre hydratant; le matin, ajoutez une protection SPF.
✓ Ne pas utiliser de produits avec huiles végétales comédogènes favorisant les points noirs.
✓ Évitez le contour des yeux et des lèvres. Si picotements persistants, espacez les applications ou réduisez la fréquence d'usage du Soin Flash Boutons et du Sérum Concentré Purifiant.
✓ Eviter l’alimentation trop grasse et/ou trop sucrée favorisant l’inflammation et l’apparition d’imperfections.
✓ Évitez l'exposition directe au soleil juste après l'application du Soin Flash Bouton ou du Sérum Concentré Purifiant, car la présence d'acides pourrait entraîner des irritations cutanées.
✓ Argile Verte (Masque) : Absorbe efficacement l’excès de sébum et empêche son accumulation afin de prévenir l’apparition de boutons.
✓ Acide Azélaïque (Soin Flash Boutons) : limite la prolifération de bactéries responsables des boutons et atténue les marques post-bouton grâce à son action anti-pigmentaire.
✓ Acide Salicylique (Gel Nettoyant, Sérum Purifiant, Soin Flash Boutons) : Exfoliant naturel qui élimine les impuretés à la surface de la peau et lutte efficacement contre les imperfections et booste le renouvellement cellulaire naturel de la peau.
✓ Zinc PCA (Sérum Purifiant) : Naturellement synthétisé par la peau, il réduit la prolifération des bactéries responsables de l'apparition des imperfections.
✓ NMF (Gel Nettoyant): Prévient la déshydratation, préserve la barrière cutanée et limite les tiraillements et dessèchement
✓ Prébiotiques (Gel Nettoyant, Sérum Purifiant, Masque, Soin Flash Boutons) : Boostent les bonnes bactéries présentes sur la peau et luttent contre les mauvaises bactéries favorisant les imperfections.
✓ Vitamine E + Actif anti-pollution (Fluide) : protègent la peau des agressions extérieures (UV, pollution) et préviennent les premiers signes de l’âge.
✓ Trio d'Acides Hyaluroniques (Fluide) : hydrate la peau en surface comme en profondeur pour plus de souplesse et d’élasticité.
✓ Trio de Céramides encapsulés (Fluide) : renforce la barrière cutanée, limite la perte en eau et maintient l’hydratation durablement.
Gel Nettoyant Purifiant
Aqua (water), Propanediol, Caprylyl/capryl glucoside, Erythritol, Glycerin, Sodium PCA, Salicylic acid, Coco-glucoside, Decyl glucoside, Xanthan gum,Chlorella vulgaris (chlorella) extract, Sodium hydroxide, Sodium benzoate, Citric acid, Lactic acid, Parfum (fragrance), Tetramethyl Acetyloctahydronaphthalenes, CI 19140 (yellow 5), CI 42090 (blue 1)
Masque stick Peau Nette
Aqua (Water), Kaolin, Glycerin, Butylene glycol, Sodium stearate, Propanediol, Illite, CI 77007 (Ultramarines), Erythritol, Cucumis sativus (Cucumber) fruit extract, Chlorella vulgaris extract, Aloe barbadensis leaf juice powder, Montmorillonite, Gellan gum, Menthyl lactate, Sodium hydroxide, Lactic acid, CI 77492 (Iron oxides), Parfum (Fragrance), Tetramethyl acetyloctahydronaphthalenes
Sérum Concentré Purifiant
Aqua (Water), Coco-Caprylate/Caprate, Niacinamide, Arginine, Butylene Glycol, Pentylene Glycol, Bambusa Arundinacea Stem Extract, Salicylic Acid, Zinc PCA, Inulin, Succinoglycan, Starch Acetate, Hydroxyacetophenone, Sodium Stearoyl Glutamate, Hydroxyethylcellulose, Xanthan Gum, Citric Acid, CI 77288 (Chromium Oxide Greens), Parfum (Fragrance), Tetramethyl Acetyloctahydronaphthalenes
Fluide Hydratation Intense SPF30
Aqua (Water), Dicaprylyl Carbonate, Propanediol Dicaprylate, Glycerin, Coco-Caprylate/Caprate, Diethylamino Hydroxybenzoyl Hexyl Benzoate, Bis-Ethylhexyloxyphenol Methoxyphenyl Triazine, Ethylhexyl Triazone, Potassium Cetyl Phosphate, Silica, Diethylhexyl Butamido Triazone, Polyglyceryl-3 Stearate/Sebacate Crosspolymer, Tocopherol, 1,2-Heptanediol, Hydroxyacetophenone, Pongamia Pinnata Seed Extract, Xanthan Gum, Hydrolyzed Hyaluronic Acid, Sodium Hyaluronate, Hydrogenated Lecithin, Ceramide Np, Ceramide Ng, Ceramide Ap, Hydrolyzed Sodium Hyaluronate, Phytosterols, Hexyldecanol, Ceramide Eop, Limnanthes Alba Seed Oil, 1,2-Hexanediol, Acrylates/C10-30 Alkyl Acrylate Crosspolymer, Biosaccharide Gum-4, Citric Acid, Sodium Hydroxide, Parfum (Fragrance)
Soin Flash Boutons
Aqua, Alcohol denat, Azelaic acid, Propanediol, Glycerin, Salicylic acid, Zinc PCA, Xanthan gum, Acacia senegal gum, Epilobium fleischeri flower/leaf/stem extract, Levulinic acid, Sodium levulinate, Citric acid
- Marie-Christine P.Acheteur vérifiéRédaction d'avisFluide Hydratation Intense SPF30Je recommande ce produitComment qualifieriez-vous votre peau ? MixteQuel âge avez-vous ? Plus de 45Noté 5 sur 5 étoilesMar 2, 2026Ne changez rien
Tjrs aussi satisfaisant tant la texture que le parfum et sa protection
Cela a-t-il été utile ? - Léa K.Acheteur vérifiéRédaction d'avisSérum Concentré PurifiantJe recommande ce produitNoté 5 sur 5 étoilesMar 1, 2026Sérum purifiant
Commandé une deuxième fois j'ai beaucoup moins de boutons
Cela a-t-il été utile ?
la routine complète


Huile Lactée Démaquillante
Huile de Ricin + Huile d'Amande Douce
- Fréquence : Soir
- Action : Élimine les impuretés grasses (maquillage, filtres UV, ect.)


Gel Nettoyant Purifiant
Acide Salicylique 2% + Prébiotiques + NMF
- Fréquence : Matin & Soir
- Action : Réduit visiblement l'excès de sébum et nettoie les impuretés en douceur


Masque stick Peau Nette
Argile Verte + Prébiotiques
- Fréquence : 1 à 2 fois par semaine
- Action : Absorbe l'excès de sébum et prévient l'apparition d'imperfections


Sérum Concentré Purifiant
Acide Salicylique 2% + Zinc PCA 1%
- Fréquence : Matin & soir
- Action : Réduit les imperfections et resserre les pores


Fluide Hydratation Intense SPF30
Acides Hyaluroniques + Céramides encapsulées
- Fréquence : Matin
- Action : Hydrate et prévient les marques post boutons


Soin Flash Boutons
Acide Azélaïque 10% + Acide Salicylique 2% + Prébiotiques
- Fréquence : 3 fois/jour
- Action : Réduit visiblement les boutons
FAQ
Oui, notre Gel Nettoyant Purifiant convient à tous les types de peau, même les plus sensibles.
Le Gel Nettoyant Purifiant est spécialement conçu les peaux mixtes à grasses : il nettoie en profondeur et purifie la peau. Sa formule, enrichie en Acide Salicylique exfolie en douceur la peau pour éliminer les cellules mortes, réduire l’excès de sébum et resserrer les pores tout en rééquilibrant le microbiome grâce aux Prébiotiques.
La Gelée Active Nettoyante enrichie en Acide Hyaluronique et Céramide préserve la barrière protectrice de la peau apporte et de la fraîcheur aux peaux les plus déshydratées.
Non, notre Masque stick Peau Nette a été formulé avec des actifs purifiants comme l’argile verte mais également des prébiotiques qui boostent les bonnes bactéries présentes sur la peau et rééquilibrent le microbiome à la surface de l’épiderme. Il laisse la peau douce sans l’assécher.
Le sérum contient la plus haute concentration en actifs autorisée soit 2% d’Acide Salicylique et 1% de Zinc PCA afin d’éliminer tous types d’imperfections (boutons, pores, points noirs, excès de sébum) de manière efficace et durable.
Nous ne voyons pas de contre-indications à l'utilisation de notre fluide sur les peaux atopiques, mais en cas de problématique très spécifique, il est important d'interroger un pharmacien ou un dermatologue pour se faire prescrire un soin spécialisé de dermocosmétique. Ce produit n'est pas traitant.
Le Sérum est un booster d’hydratation : il hydrate toutes les couches de la peau grâce à différents types d’Acide Hyaluroniques et booste naturellement la synthèse d’Acide Hyaluronique grâce au Glycogène.
Le Fluide Hydratation Intense renforce la barrière protectrice de la peau pour sceller l’hydratation et la protéger de toutes les agressions extérieures (UVA & UVB, lumière bleue, pollution) pour prévenir le vieillissement prématuré.
Le Soin Flash Boutons est un soin ciblé qui doit être utilisé aussi souvent que nécessaire et de manière locale. Pour booster les résultats d’efficacité sur la réduction des imperfections, il est recommandé d’utiliser en complément notre Sérum Purifiant Concentré.
Le retour de votre commande est accepté, à condition que votre demande de rétractation soit faite sous un délai de 14 jours à partir de la date de livraison. Les frais de retour seront à votre charge.
Nos produits sont disponibles en pharmacies et parapharmacies; mais aussi chez Sephora et Monoprix. Vous pouvez retrouver nos points de vente sur cette carte https://www.respire.co/pages/ou-nous-trouver






